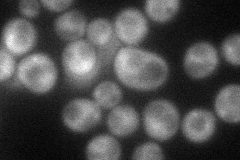
YKR021W
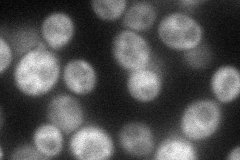
YKR021W
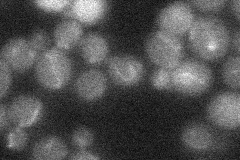
YKR021W
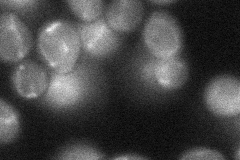
YKR021W
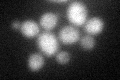
YKR021W
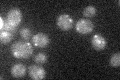
YKR021W

View description
Protein proposed to regulate the endocytosis of plasma membrane proteins by recruiting the ubiquitin ligase Rsp5p to its target in the plasma membrane; green fluorescent protein (GFP)-fusion protein localizes to the cytoplasm
Localization:
Intensity:
Fold change:
Significance:
-
C’ GFP library in SD

cytosol22.77 -
N' NOP1pr-GFP in SD
cytosol52.4506 -
N' TEF2pr-mCherry in SD
cytosol55.8939 -
N' NATIVEpr-GFP in SD
below threshold19.451 -
N' TEF2pr-VC and Cyto-VN in SD
cytosol,punctate39.7762 -
C’ GFP library in SD+DTT
cytosol24.61.08No -
C’ GFP library in SD+H2O2

cytosol22.60.99No -
C’ GFP library in Starvation Media
punctateN/AN/AYes -
C’ GFP library on the background of Pup2-DaMP

cytosol -
C’ GFP library on the background of CCT mutant

cytosol20.67390.907527No
